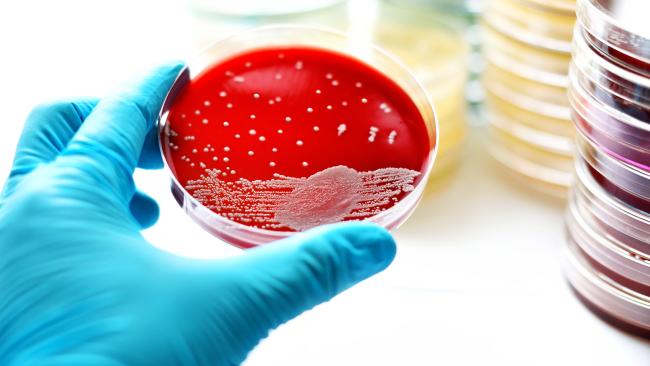

A la chita callando, como quien no quiere la cosa, haciéndose el longuis, silbando disimuladamente… Así ha lanzado Telecable de Asturias una de las mejores ofertas móviles del mercado. En varias ocasiones hemos avisado de que 2017 sería el año de las tarifas con muchos gigas a buen precio, y aquí tenemos otra prueba con una tarifa de 20GB por 30€ con llamadas y SMS ilimitados.

Los asturianos ofrecen esta propuesta, que compite con los 25GB de la Sin Fin de Yoigo por 32€, en todo el territorio nacional. Si bien sólo en el Principado puede disfrutarse de las ventajas de Wifisfera, la red de wifi comunitaria en la región. Pero claro, con 20GB tampoco es que haga demasiada falta.
Sólo 3G, hasta el verano
Estos precios han sido posibles gracias al reciente acuerdo mayorista firmado con Movistar, e incluirán 4G. Sin embargo, en esta primera fase la compañía todavía depende de la red de Vodafone. Fuentes de la operadora confirmaron que todos los clientes experimentarán el cambio de cobertura automáticamente y sin necesidad de cambiar la tarjeta SIM a partir del verano, muy probablemente desde el mes de junio.
Telecable generó unos ingresos de 100,8 millones el año pasado en el sector consumo, un 1,9% más, con un incremento de los ingresos medios por cliente del 5,9%, de 57,3€/mes hasta 60,8€. «Estos incrementos más que compensan el impacto de la reducción en número de clientes totales debida a la actividad promocional a corto plazo de otros operadores que han invertido en FTTH en Asturias durante los últimos años», subraya la compañía. En todo caso, la competencia tampoco ha arañado mucho. Telecable ha perdido 6.000 clientes en todo el año, quedándose en 138.000. Contando empresas, los ingresos suben hasta 138,5 millones.
Subidas de precios
Durante el año pasado la compañía también subió precios. Concretamente, dos veces. Subió 2€ los productos combinados en enero de 2016 e hizo segunda subida de 3€ en septiembre. Estas alzas, como las que viene sufriendo todo el sector, fueron acompañadas de mejoras en los servicios de los clientes, como duplicar el número de megas de la franquicia de datos, y llevar a 200Mbps la velocidad mínima de conexión. Pero uno de los principales motivos, y la operadora lo reconoce, ha sido la fuerte inversión necesaria para poder ofrecer el fútbol en su televisión.
Concretamente, los ingresos de móviles se elevaron en un 10,3%, hasta 28,8 millones, y la penetración del cuádruple play (móvil, fijo, televisión e internet) alcanzó la cifra récord del 37% durante el año. La compañía entró en 2016 en un beneficio operativo de 3,4 millones de euros, si bien los costes de financiación de su adquisición por Zegona provocan que el resultado neto arroje unas pérdidas de 6,3 millones de euros, mucho menos de la mitad de los 15,1 millones que se anotó en 2015.